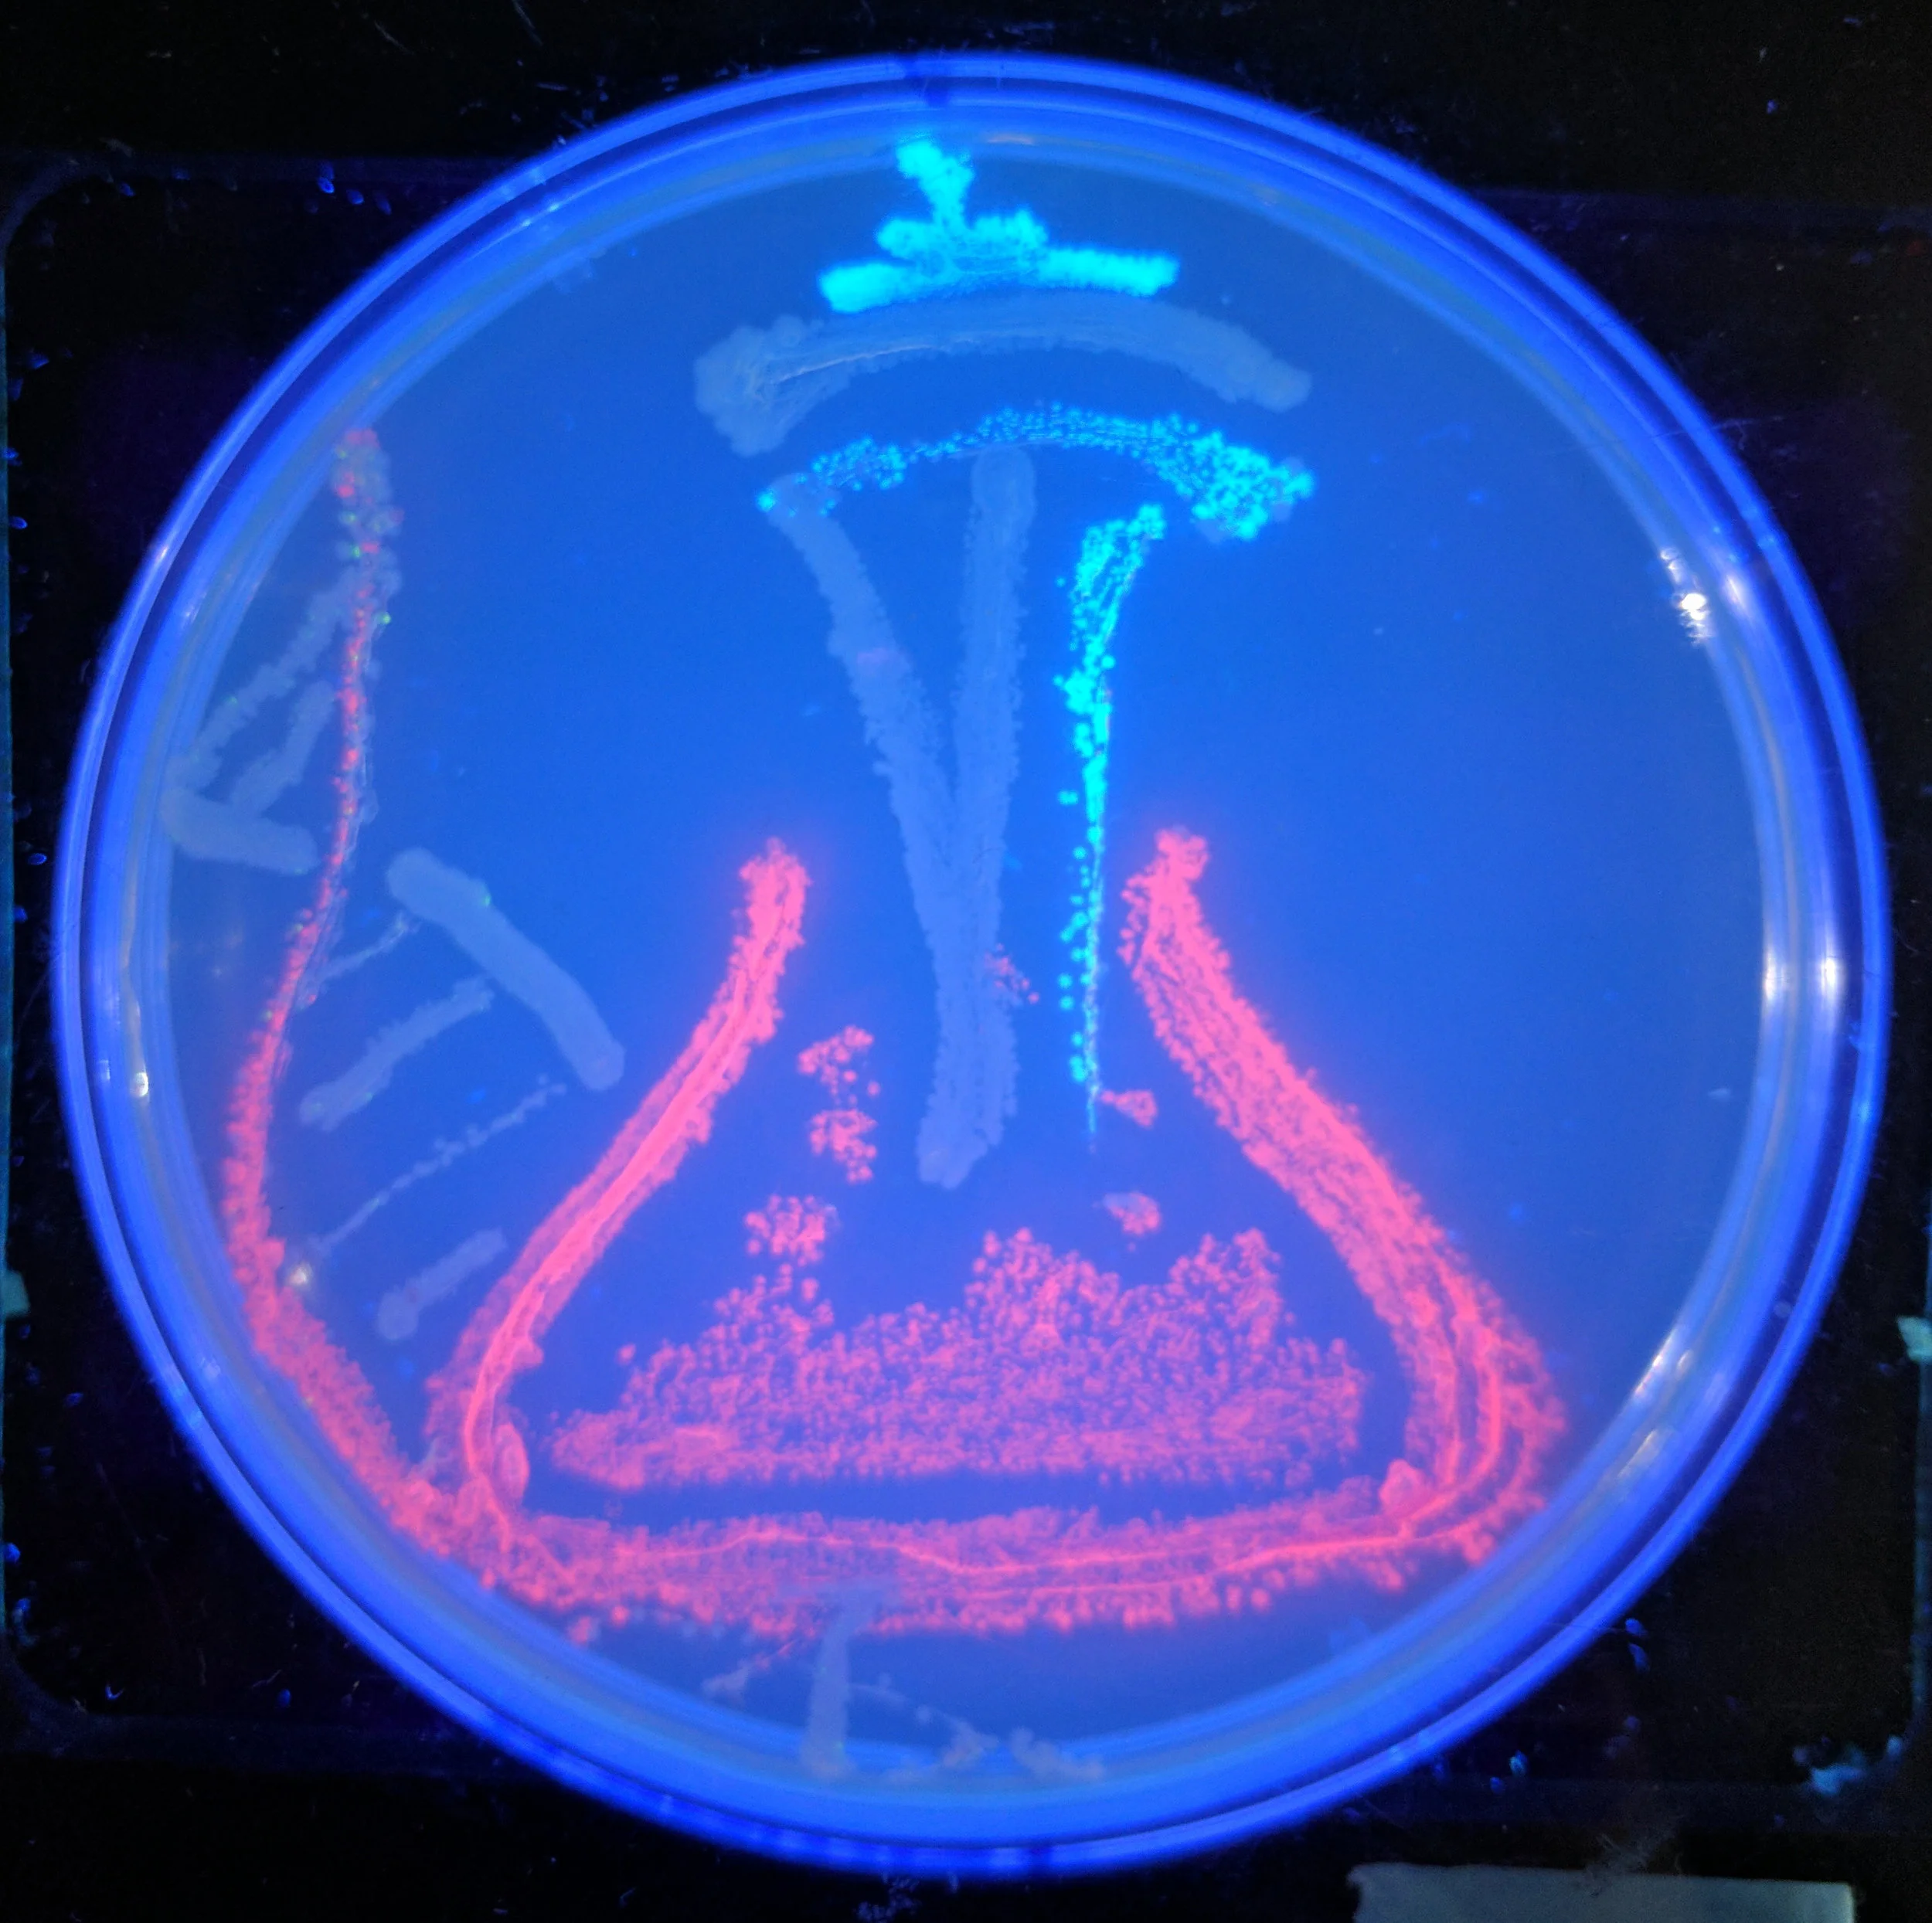
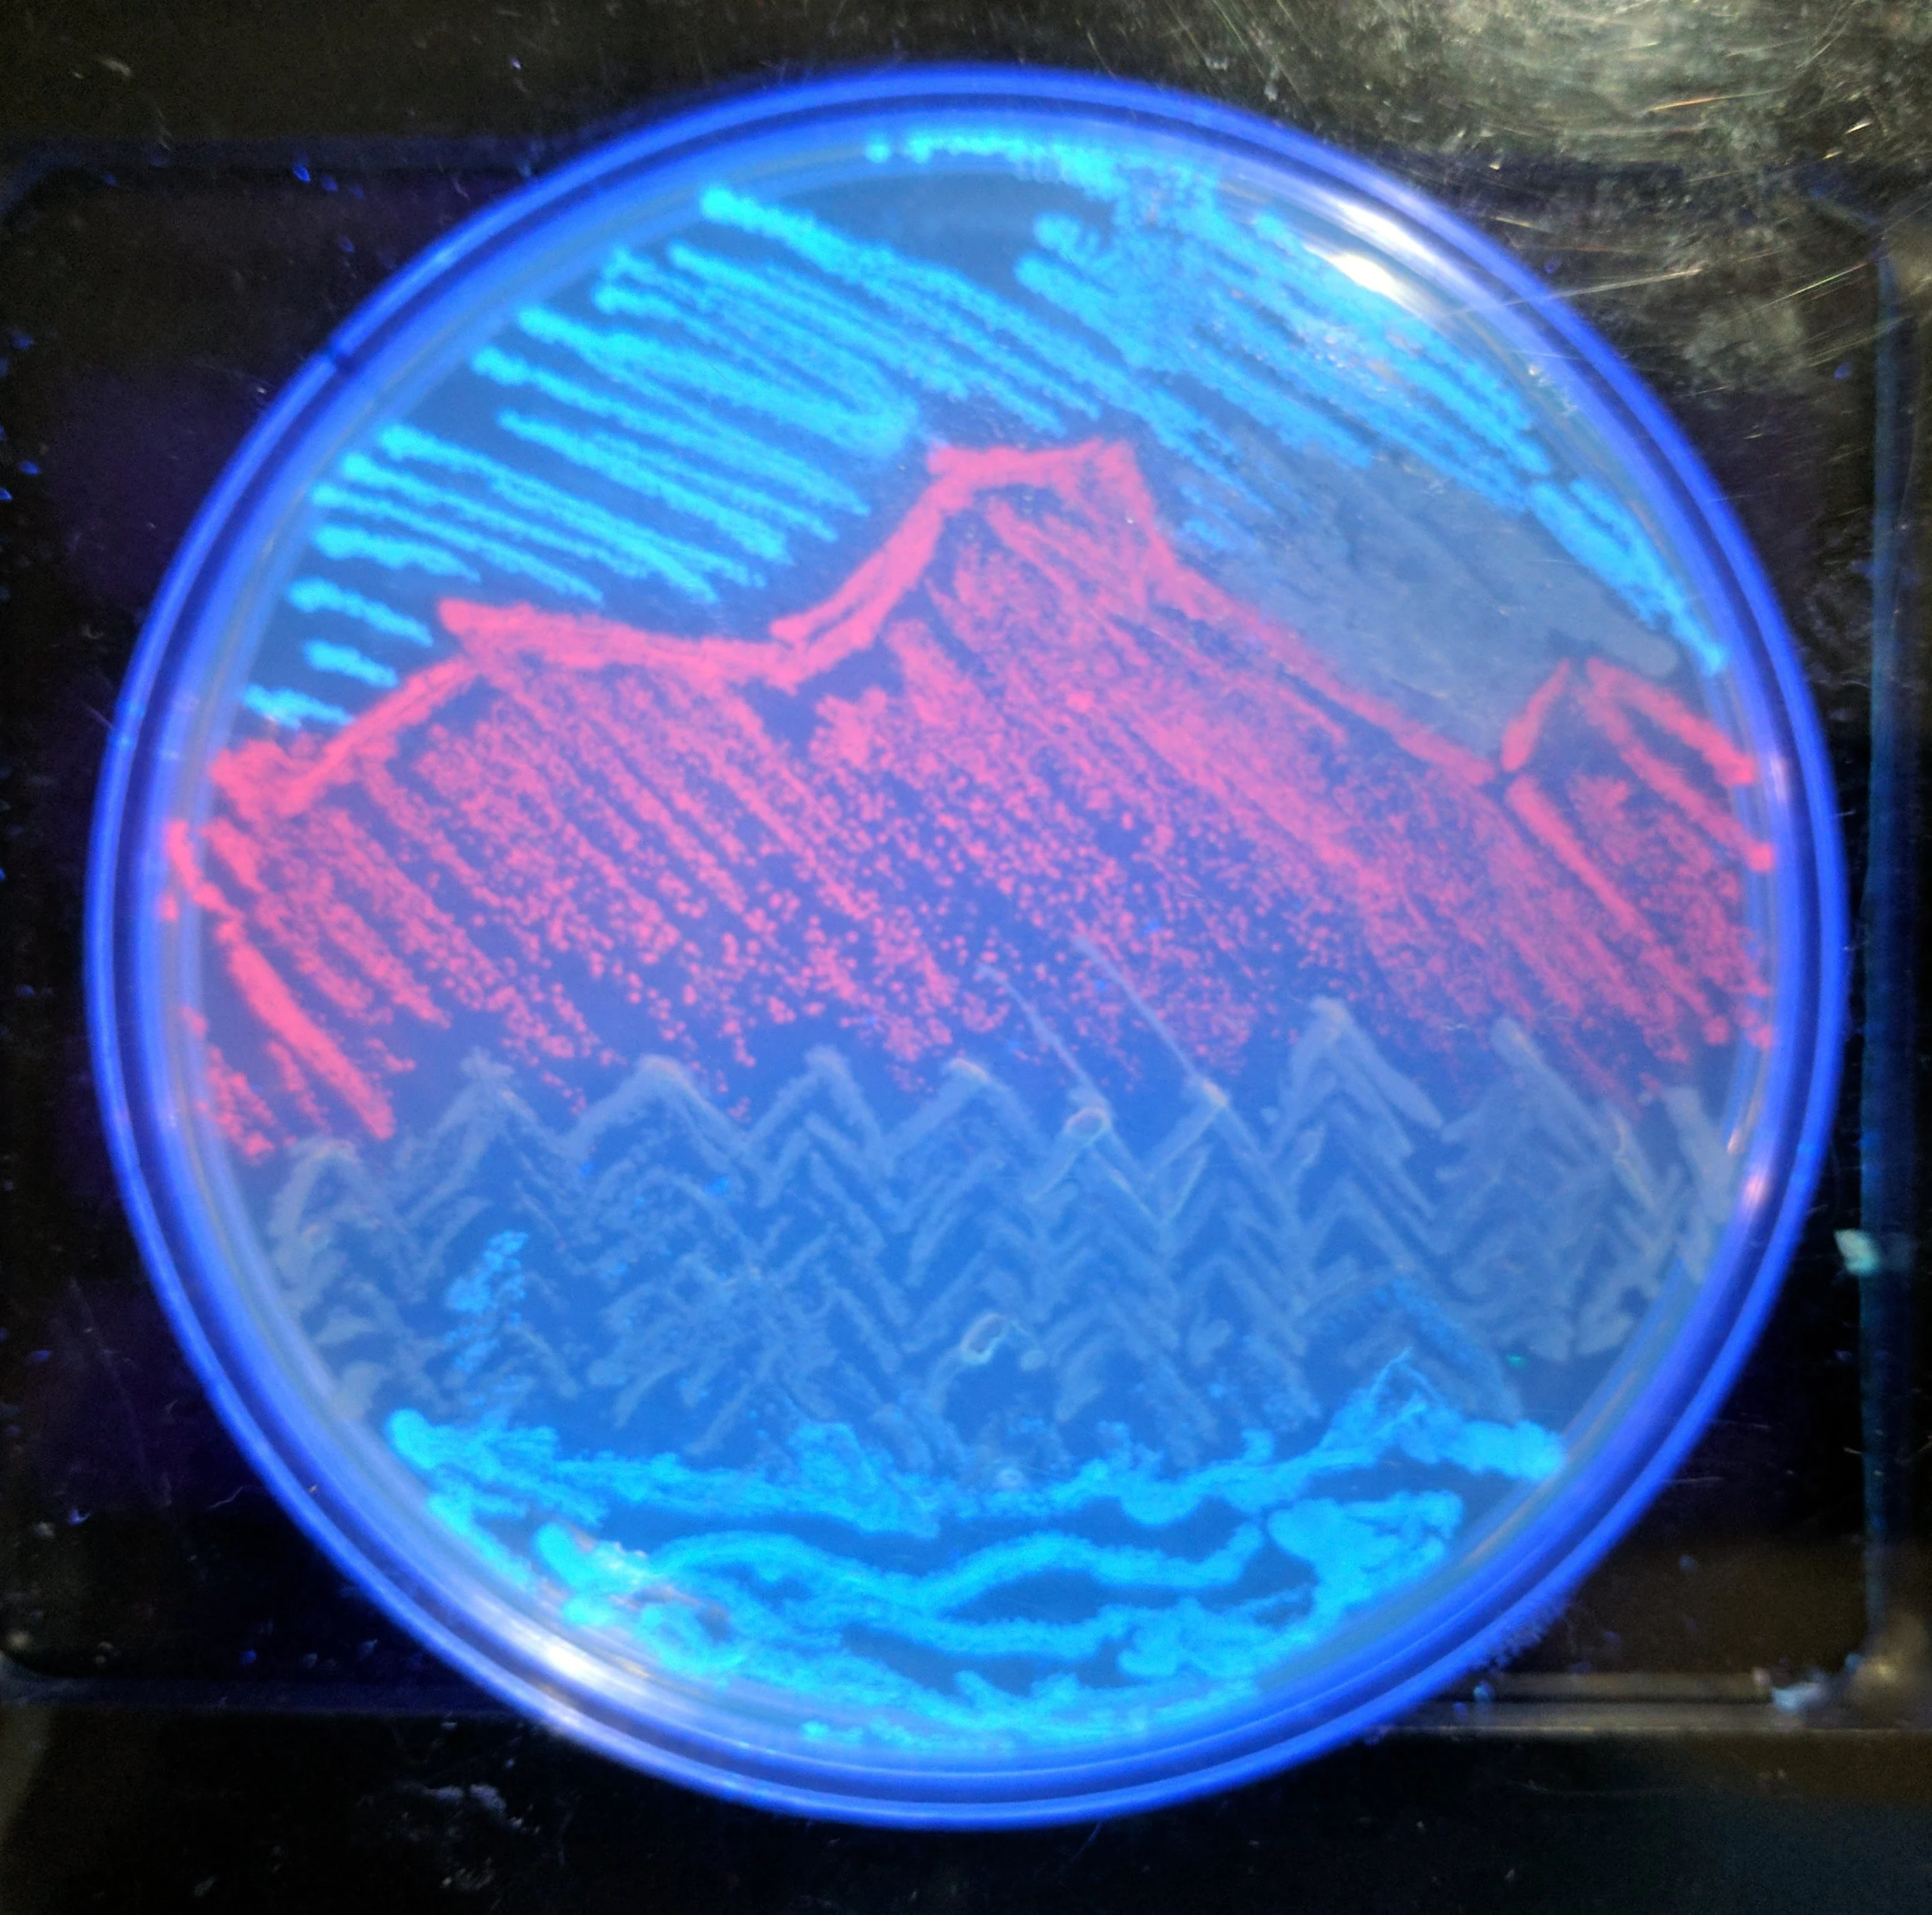
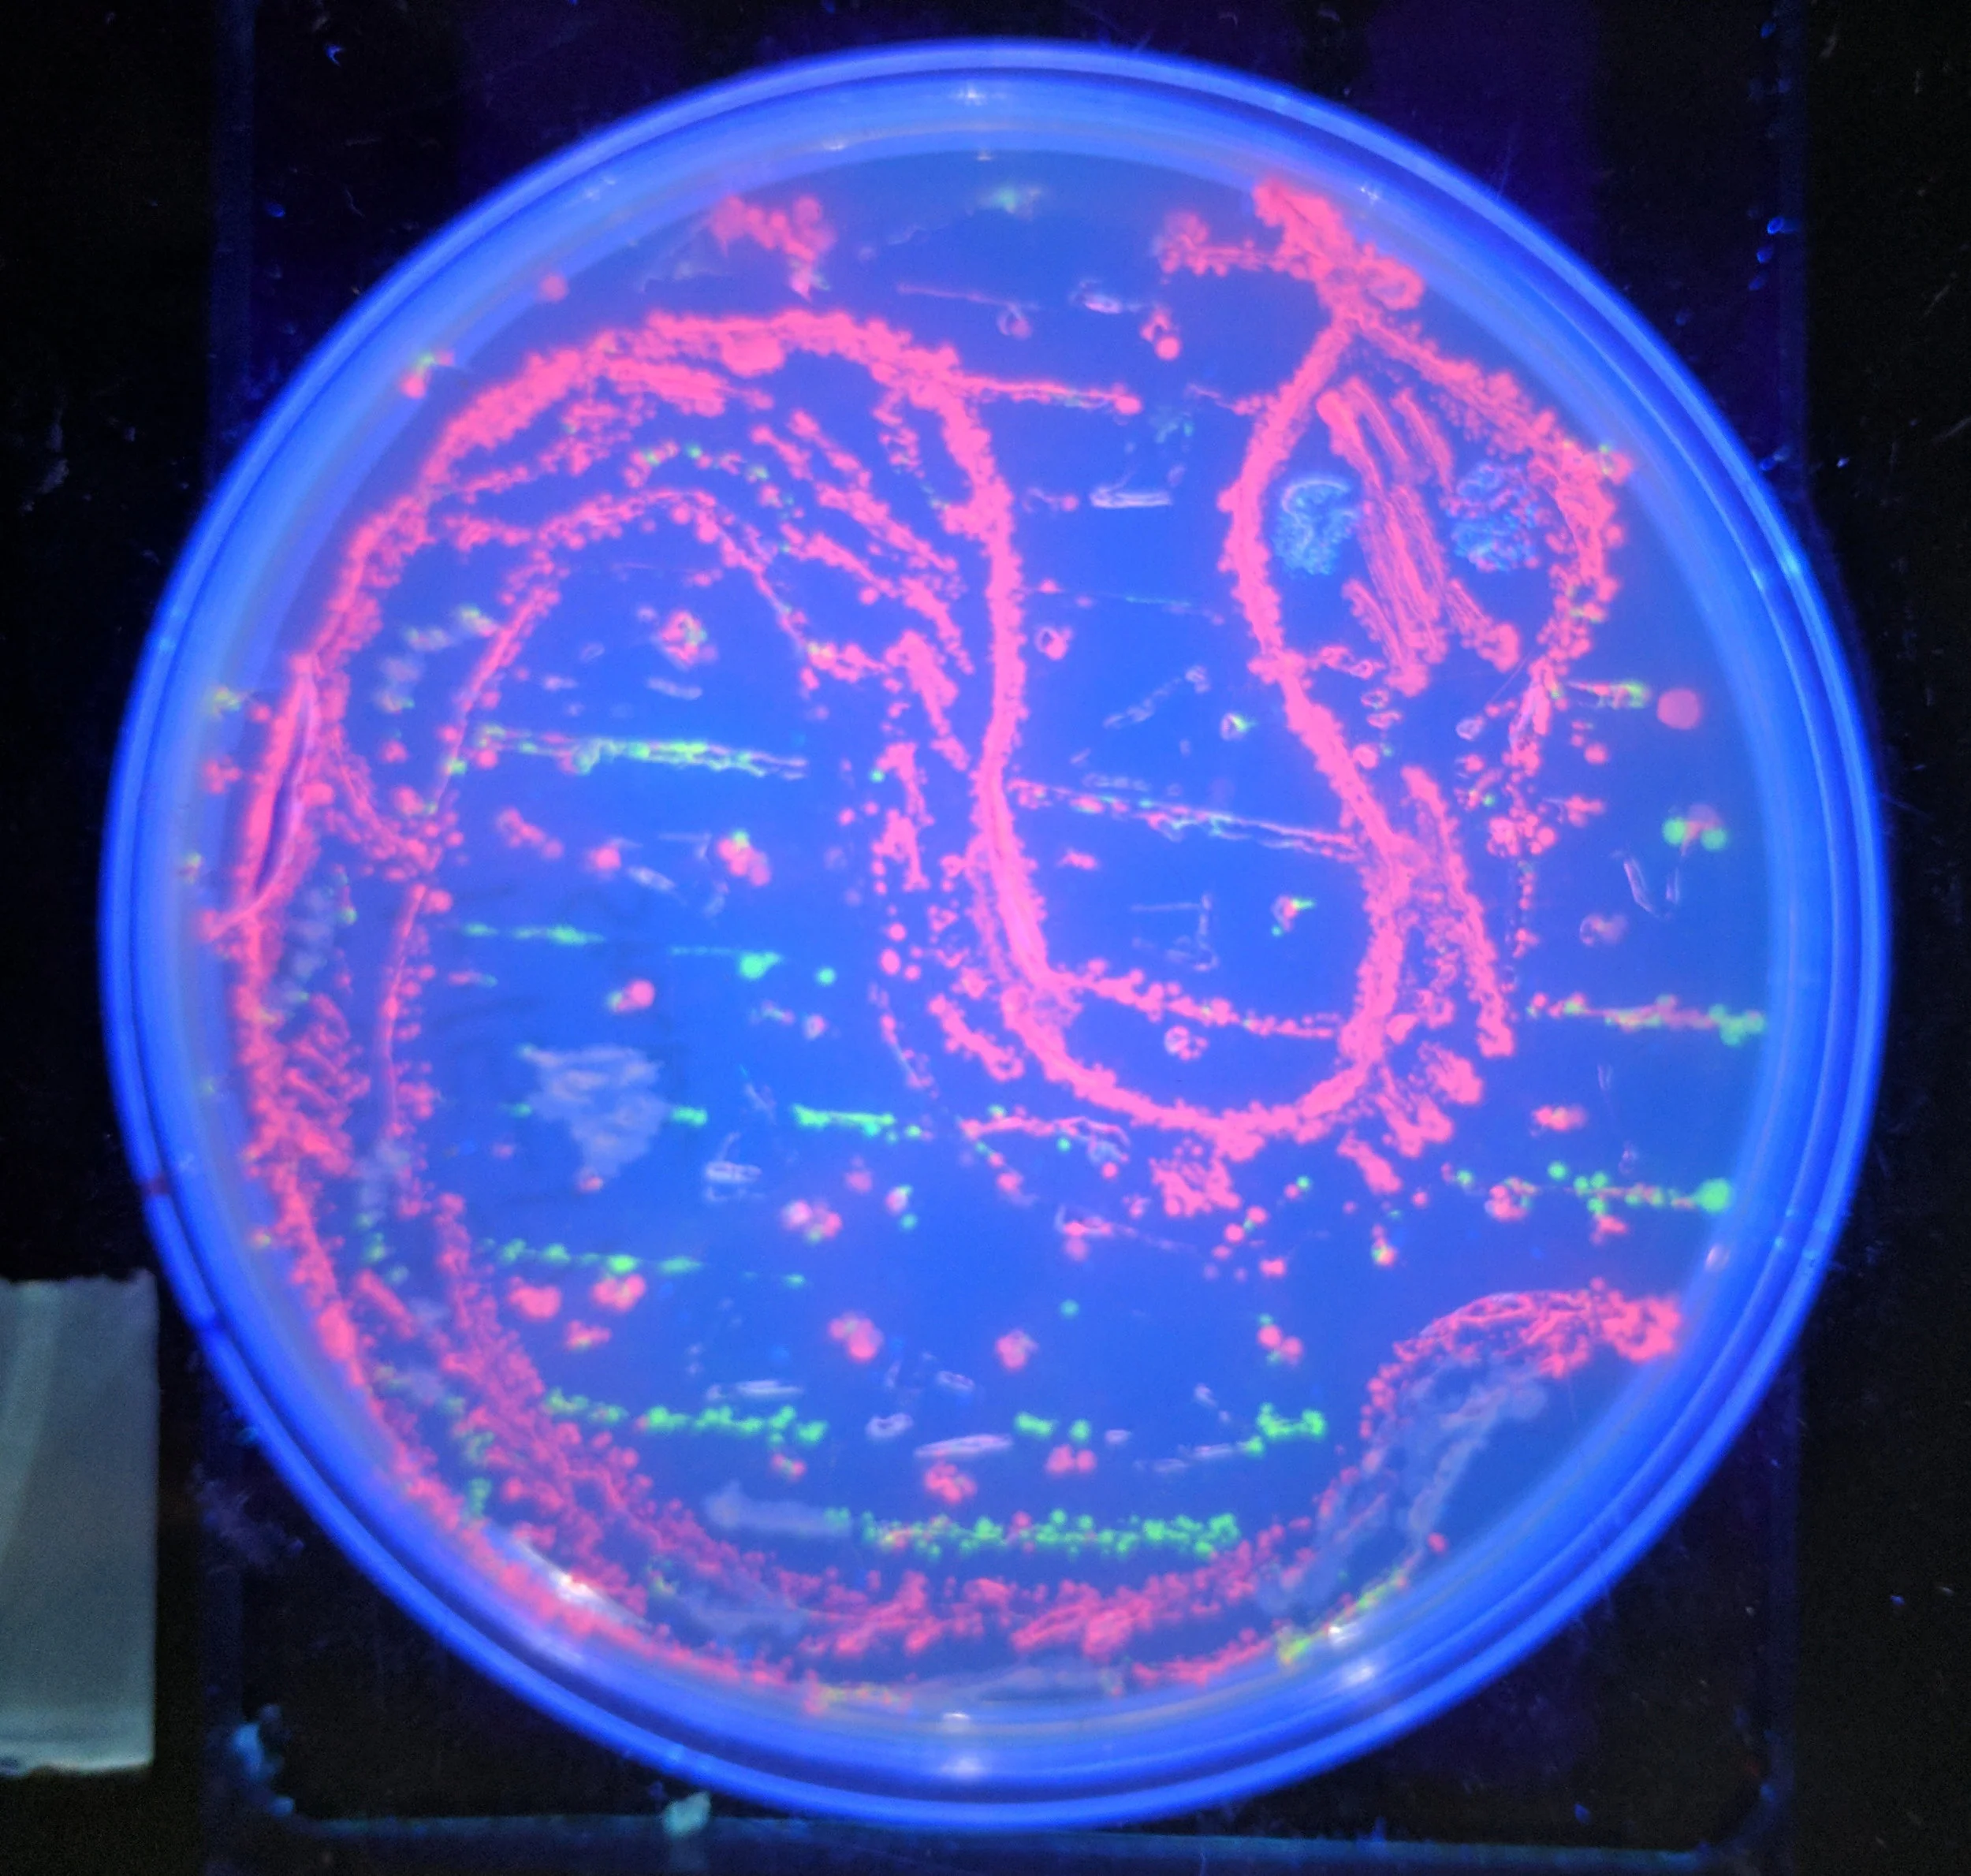
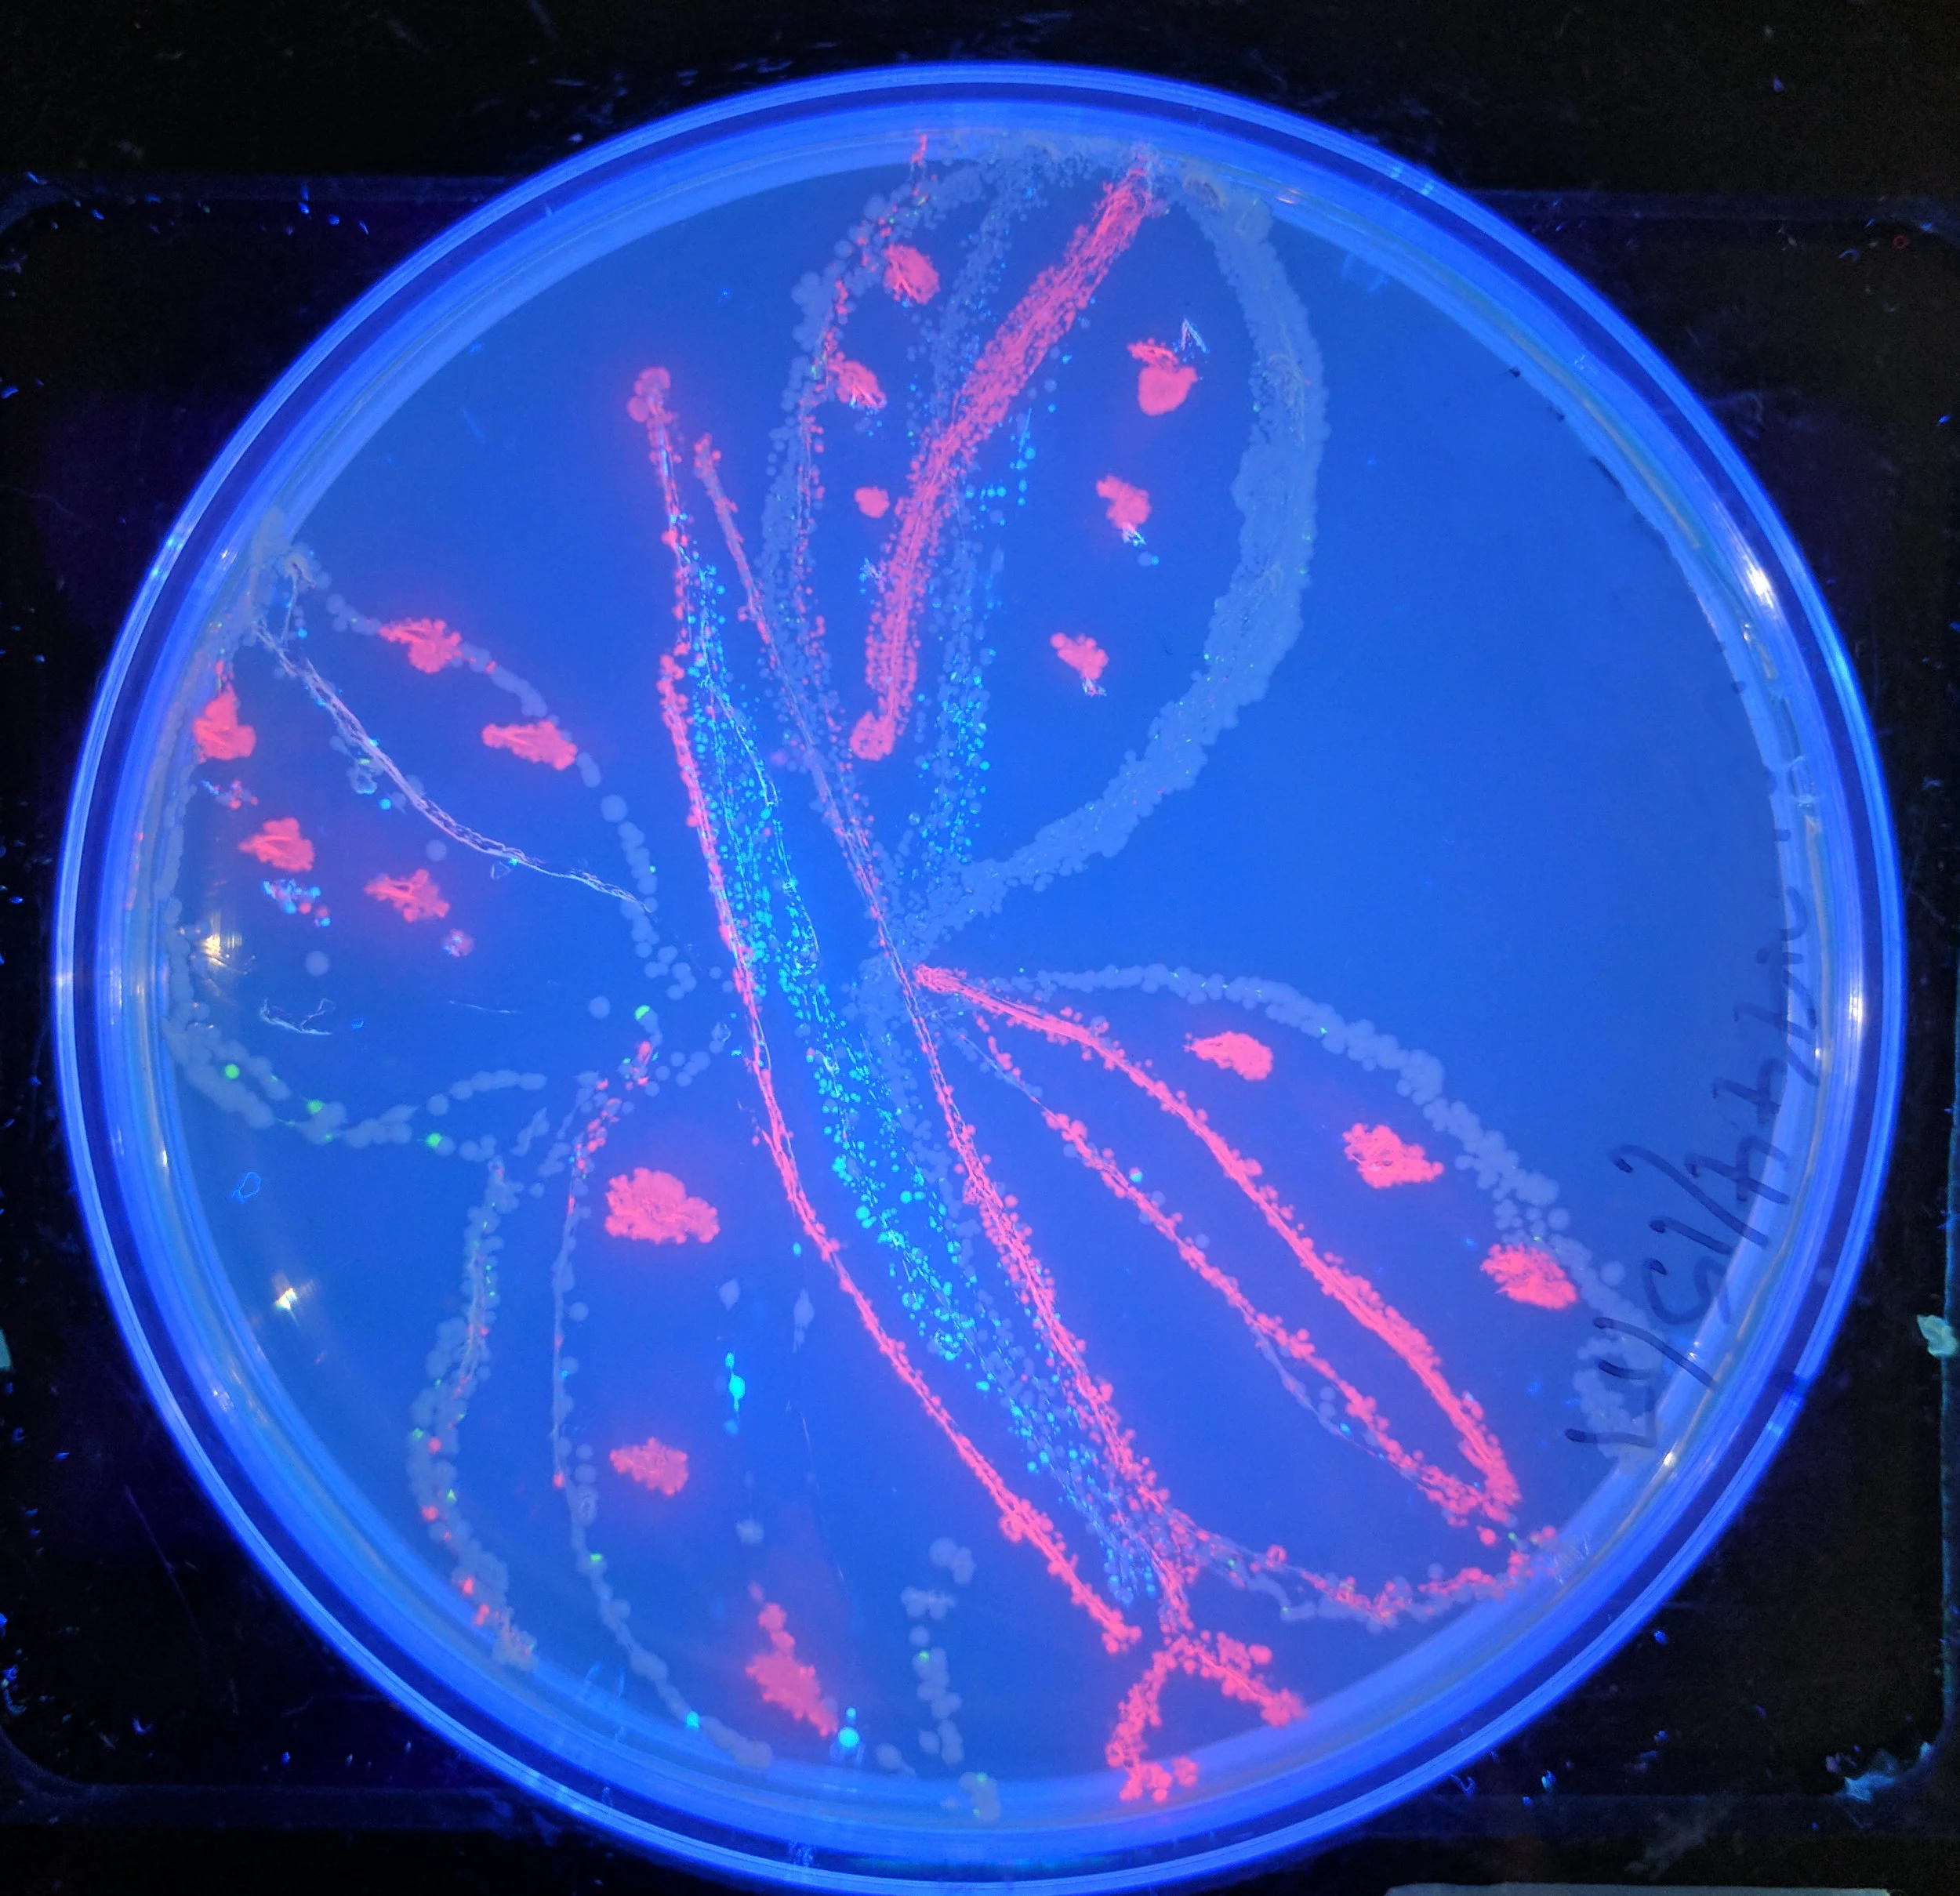

Check Out Our Past Events!
RECENT WORKSHOPS (IN PERSON)
ALGAE HAPPY HOUR (VIRTUAL)
RECENT WORKSHOPS (VIRTUAL)
SBL BOOK CLUB (VIRTUAL)
BE a scientist for a Day - Sponsored by Celgene (Nov 3, 2018)
27 eager middle school students joined us at Celgene’s Juno location for a morning of science fun!
Maker Day at MOHAI (OcT 27, 2018)
We had a great Maker Day event at MOHAI where we painted with bacteria - learn more about it on our blog post!
AmAZon Women in Engineering Tech EXPO (Sept 29th, 2018)
We have a great time presenting our filtration challenge at Amazon’s 4th annual Women in Engineering (AWE) Tech Expo event. Check out the amazing 3D printed heels on display at our neighboring booth!
museum of flight maker night (Sept 19, 2018)
© The Museum of Flight
Probably our coolest outreach backdrop to date! The Museum of Flight's Boeing Academy for STEM Learning maker night was a sold-out event and a great evening of science! Learn about their Connections program that made this possible here!
Seattle Mini Maker Faire (Aug 18-19, 2018)
SoundBio Lab presented 2 different activities at our Maker Faire table; the Black Box Challenge and the Filtration Challenge. Both children and adults had a great time figuring them out!
wash state department of health lab tour (July 12, 2018)
Our tour included divisions of Epidemiology, Environmental Sciences, Newborn Screening, and Infectious Diseases. This facility services the entire state of WA and does work on a wide variety of infectious diseases and contaminants in our environment. They also handle BSL level 3 activities (such as TB). According to their website, they "provide diagnostic and analytical services for the assessment & surveillance of infectious, communicable, genetic, and chronic diseases and environmental health concerns". We met a wonderful and dedicated group of researchers and administrative personnel!
Wedgwood elementary science night (may 17, 2018)
shoreline stem festival (May 5, 2018)
jane addams middle school steam fair (may 3, 2018)
john rogers stem night (Apr 20, 2018)
multicultural family potluck dinner & science fair (mar 15, 2018)
olympic view science night (feb 8, 2018)
A great evening at Olympic View elementary teaching curious kiddies how to use a dropper to practice beginning pipetting skills! Everyone wore their microtube necklaces with pride.
iGEM giant jamboree, boston (NOV 9-13, 2017)
Team iTesla-SoundBio took home a bronze metal at the iGEM Giant Jamboree in Boston!
global community bio summit, MIT Media Lab (Sept 22-24, 2017)
SoundBio flew coast-to-coast for a weekend of participation at the GCBS 2017 in Boston and one of our projects, Citizen Salmon, presented. Watch the talk here!
Mini Maker Faire, Museum of pop culture (Sept 16-17, 2017)
A perfect Fall weekend at the MoPop for hands-on science activities for adults and children alike!
BIoHack THe planet conference, Oakland, Ca (Aug 25-26, 2017)
We had a productive few days of discussion, collaboration and presentation with like-minded biohackers at the BioHTP conference in California! Check out our talk here, and for last year's talk at BioHTP by one of our projects, Citizen Salmon, click here!
heart and blood workshop (Aug 5, 2017)
What a cool workshop. We learned the basics of blood and transport systems in a variety of organisms, how to determine our own hematocrit, our blood type by typing our own blood, a microscopic evaluation of our white blood cells using Wright’s stain, using a stethoscope, dissection of a mammalian four-chambered heart, cardiac electrophysiology, and performing an ECG! Now that's what we call DIY bio!
science talks with uw Genomics salon (Aug 4, 2017)
We had five researchers from the University of Washington give lightning-round talks on the foundations of the genome, utilizing yeast to interpret the genome, the importance of glowing proteins, the complex relationship between data and "self", and the application of critical thinking with regards to scientific data in the news. It was a fun and entertaining way to learn and we'll be sure to do this again in the future! For more information about the Genomics Salon, check them out here!
uw robinson center for young scholars camp (july 20-21, 2017)
We partnered up with an educator at the Robinson Center during their summer program so that her students could get some hands-on laboratory experience, and it was such a pleasure having them! They learned how to micropipette like experts and then ran through their own DIY electrophoresis from start to finish. Bravo young scholars!
Sacajawea boys & Girls Club (july 17, 2017)
We have an ongoing program with the Sacajawea Boys' and Girls' Club. In a series of events, kids get to learn about different scientific topics from sound waves to DNA. Always a fantastic time!
nite at the lab series: board games (july 14, 2017)
Henrici et al
In our second installment of the DIYBio Hacking Series, we attempted to harvest DNA from E. coli. This is a common molecular biology procedure and critical for any recombinant DNA labwork. The DNA we worked with was created by Penn State Uni as a more affordable alternative to commercial DNA ladders for gel electrophoresis. We'll be testing this in our lab and hopefully using it in future hacking sessions!
Junior Science night at the lab (June 17, 2017)
Occasionally we let little ones in for a tour, and they love learning about all the equipment it takes to run a biology laboratory! Check out our Facebook page to see more photos!
washington homeschool org convention (June 16-17, 2017)
We had a great weekend at the 2017 WHO Convention held at the Washington State Fair in Puyallup. We had several tables filled with lots of fun activities! Our favorite quote of the day from one young participant: "Thank you for facts." You are most welcome. Check out more photos from the event here!
light microscopy workshop (june 3, 2017)
Participants learned all about one of the most well-used instruments in biological science; the light microscope! We examined many different materials such as cheek cells, connective tissue, tape worm, soil and pond water samples!
shoreline stem festival and science fair (may 20, 2017)
While the older students competed for prizes, the younger kids started their first scientific steps using droppers as pipettes and fun colors!
nwabr student bio expo (may 19, 2017)
Several of our colleagues were judges at the NWABR Student Bio Expo, and topics ranged from creative writing and art to molecular modeling and lab research. It was a full day of listening to high school students from all over discuss why their chosen topic was important to them and their proposals for future systematic change. "The mission of the NWABR Student Bio Expo is to provide high school students opportunities to interact with the scientific community and to engage them in new creative ways to demonstrate their understanding of biotechnology and biomedicine."
wedgwood elementary school science night (May 18, 2017)
Over 400 attendees came to this fantastic annual science event at Wedgwood Elementary!
jane addams middle school steam fair (may 10, 2017)
What a great Science, Technology, Engineering, Arts, and Math fair at this school. It was an added bonus to receive so much genuine interest and enthusiasm from a large portion of female students!
Competent Cells and Bacterial Transformations (May 8, 2017)
Khan Academy
Thanks to our good friend, Doug, for running our first dissection workshop at the lab! It was such an informative and exploratory afternoon. Check out our Facebook photo album for more images!
Whitman middle school science expo (April 27, 2017)
How many strands of DNA do you think are present?
We lucked out with our timing by engaging students in a strawberry DNA extraction exercise the week before they start to learn all about the cell! Our giveaway microtubes are perfect for storage so teachers can keep them chilled until they practice using dyes and microscopes! We got bombarded by students and it was a messy and fun-filled evening!
march for science on earth day (april 22, 2017)
Check out our new Instagram page where we decided to post our first picture (above) on Earth Day and display the eloquent message delivered by the folks mobilizing the Seattle Science March. We could not have said it better ourselves. Bravo!
March for Science Poster party (April 20, 2017)
Photo by Matt Mills McKnight/Cascade Public Media
We recently organized an evening for the community to celebrate Earth Day and create some poster art! Crosscut.com stopped by to see what we were up to, and we think they liked what they saw as they included us in their article regarding the Seattle Science March. Thanks to all who came through in solidarity for science!
painting with bacteria workshop (april 15, 2017)
We held a workshop the day before Easter to paint with (a safe form of) E. coli instead of using eggs! These are just some of the many artworks that were created!
Sacajawea boys & Girls Club (April 14, 2017)
We have an ongoing program with the Sacajawea Boys' and Girls' Club. In a series of events, kids get to learn about different scientific topics from sound waves to DNA. Always a fantastic time!
SoundBio would like to thank our grant sponsor, the National Science Foundation, for funding many of these Sacajawea workshop events and science activities!
genetic scissors workshop (April 1, 2017)
Our third and final workshop in the Lab Skills 101 Series utilized techniques gained from the previous two classes to further advance participant knowledge of DNA. We used three common restriction enzymes to cut bacteriophage DNA via preparing reagents and gels, running gel electrophoresis, and staining. It was great fun to observe positive outcomes with successful digests!
candy electrophoresis workshop (March 25, 2017)
Our second workshop in our Lab Skills 101 Series focused on learning the gel electrophoresis process using color from Skittles candy! Wakanene did an expert job at teaching the multi-step experiment to a full house. Each lab group did it all; crushed skittles, built their own chamber, created their own gel, and used electricity to separate molecules as they ran and analyzed their gel! Here's some feedback from one of our participants on Meetup: "That lab was SO fun! We (ages 13 to 50) learned a lot and plan to attend future workshops. I love how you make biology accessible to, and enjoyable by, everyone. Your passion for teaching really shows. :)" We're so pleased they loved it!
Olympic hills Science Fair (March 23, 2017)
Pipetting and liquid handling is a basic skill for all lab scientists. At the Olympic Hills Science Fair, students put their lab skills to test by pipetting colored liquids into microtubes to create necklaces!
MICROPIPETTING WORKSHOP (MARCH 18, 2017)
We held our first official workshop (Lab Skills 101 Series) in the lab following our launch party on March 11th! We had a great turnout and we are pleased to see strong interest come from many different age groups. We talked about the importance of laboratory basics and pipette-handling techniques, and then everyone got to practice and perfect their own skills via fun and engaging activities. Success!
Soundbio lab launch party (March 11, 2017)
After many months of hard work by a team of dedicated individuals, we officially opened our doors to the public! Take a look at our Facebook page for more photos of the event!
sacajawea elementary science night (march 9, 2017)
We often participate in community tabling events to spread science awareness, even when slammed with preparations for our launch opening. Here are a few of our team members setting up for a fun evening of DIY biology!
Sacajawea boys & Girls Club (February 24, 2017)
We have an ongoing program with the Sacajawea Boys' and Girls' Club. In a series of events, kids get to learn about different scientific topics from sound waves to DNA. Always a fantastic time!
Lake Forest Park Elementary Science Night (Feb 15, 2017)
Pipetting and liquid handling is a basic skill for all lab scientists. At Lake Forest Park's Science Night, students put their lab skills to test by pipetting colored liquids on 96-well plates and created microtube necklaces!
nerd night seattle: citizens in science (jan 17, 2017)
We were invited by Nerd Night Seattle to participate in their monthly event to discuss ways in which the community can become more involved with STEM research and public health advocacy. Since Nerd Night holds their event every month at High Dive Bar, we thought it was only fitting to have our project, Citizen Salmon, pull that Chinook costume back out and don it for another round on the stage.
Sacajawea boys & Girls Club (December 19, 2016)
We have an ongoing program with the Sacajawea Boys' and Girls' Club. In a series of events, kids get to learn about different scientific topics from sound waves to DNA. Always a fantastic time!
biohack the planet conference, oakland, ca (Sept 24/25, 2016)
One of our projects, Citizen Salmon, was invited to speak at the BioHTP conference in California to present their research on building a database of salmon genotypes, species identification, and DIY genotype kit creation. We donned a homemade Chinook Salmon costume for further proof that scientists not only appreciate the arts but also don't take ourselves too seriously despite the weighty work that we do. Check it out here!
Painting with bacteria @ Amazon (July 25, 2016)
We took DIYbio to Amazon's Expressions Lab where Amazonians were given the opportunity to transform E.coli to express color and paint beautiful pictures using pre-transformed glowing bacteria!
Influence of the confluence (June 11, 2016)
At Influence of the Confluence by Thornton Creek Alliance, kids and families got the chance to practice DIYbio at the SoundBio table. During the event we extracted strawberry DNA and looked at fish scales through microscopes!
Amazon mini-maker fair (March 12, 2016)
At Amazon's mini-maker fair we got to show off some cool toys and teach micropipetting!